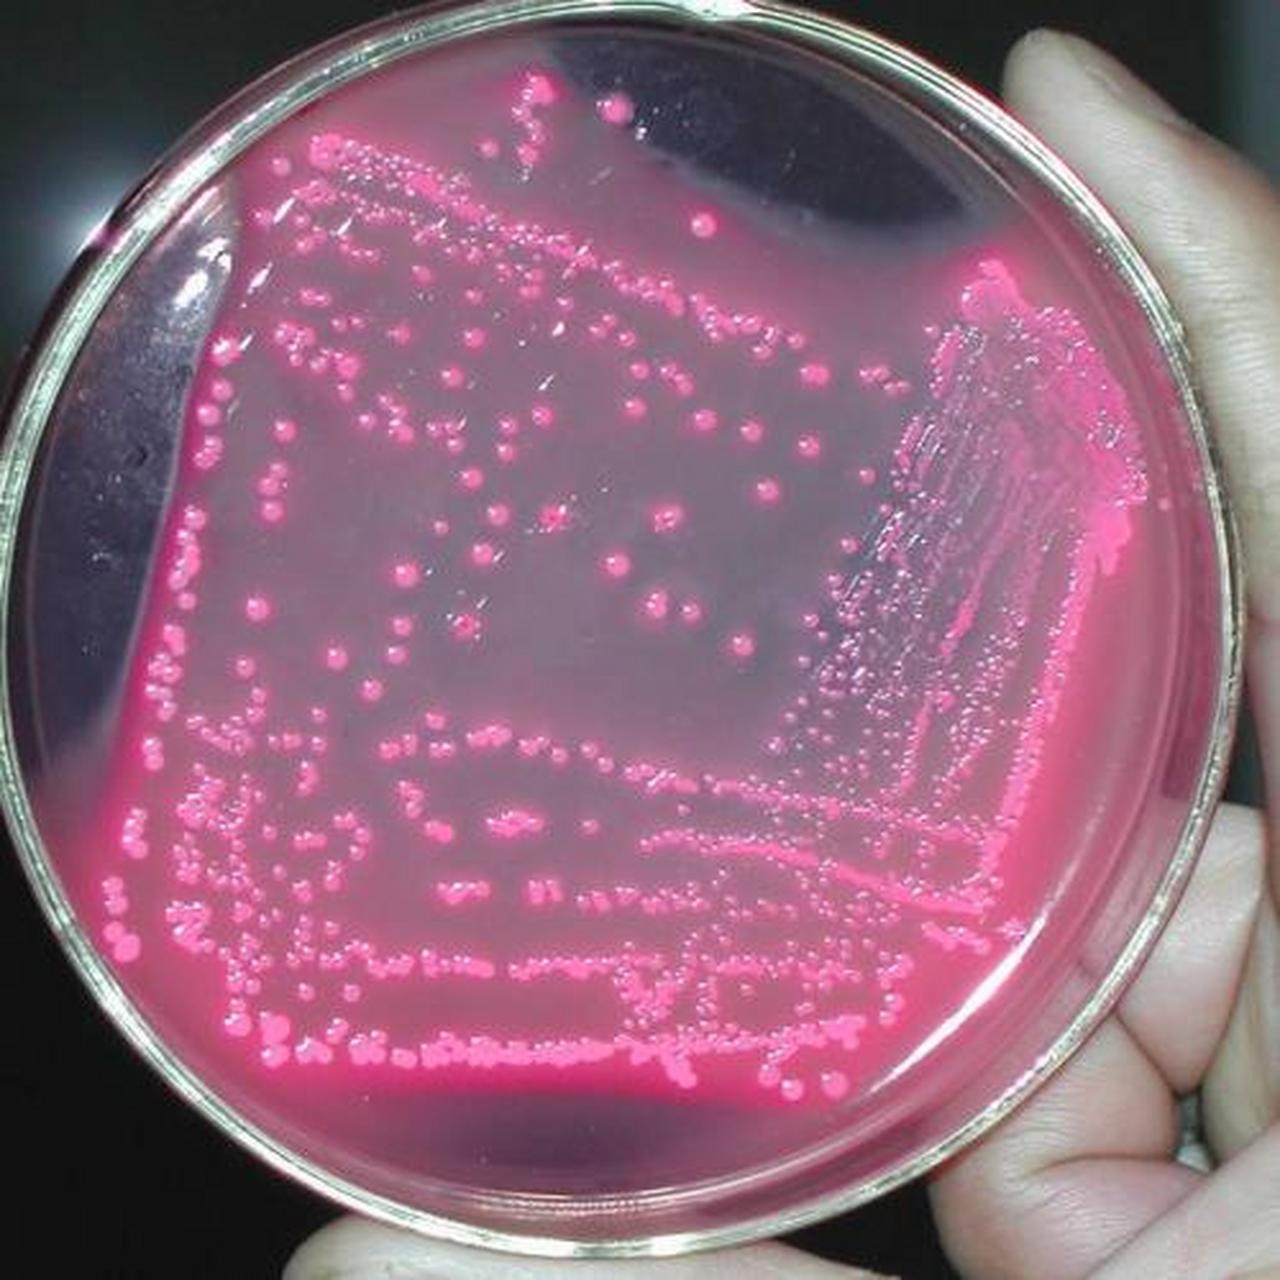
科普知识竞赛#尿酚红排泄试验(psp)是一项用于检查尿液是否正常的

酚红

胰酶细胞消化液(酚红)
图片尺寸500x500
科普知识竞赛#尿酚红排泄试验(psp)是一项用于检查尿液是否正常的
图片尺寸1280x1280
苯酚红,phenol red,cas号143-74-8,沈阳伊默克化工
图片尺寸866x866
苯酚红 143-74-8 酚红厂家
图片尺寸750x750
苯酚红
图片尺寸705x588
胰酶细胞消化液(酚红)biosharp实验室专用
图片尺寸500x500
有机颜料干粉红色粉21
图片尺寸2816x1880
酚红
图片尺寸344x300
05%), 酚红 100ml/500ml
图片尺寸1000x1000
factory sale high quality iron oxide red pigment
图片尺寸960x960![酚红 苯酚红 ind指示剂 phenol red 25g [ph0623 phygene]](https://imgs.wantubizhi.com/img/31326CE759A4D648D73F1BAC447D16C0E810A9B3DE856EA250F60E3DF0E3673F7F33FF3E3DE4A11AD15A88CAE0E1AE72C6B75DE0322AA7969223F0B1A5F66FA800B6C9032423B87889C2747219D2A761CF449D89E1A8293E6850ABB19811877B)
酚红 苯酚红 ind指示剂 phenol red 25g [ph0623 phygene]
图片尺寸800x800
麦康凯琼脂平板
图片尺寸500x484
卤肉上枣红色为什么要加紫草?红曲红在卤水中颜色变淡如何解决?
图片尺寸1280x960
丁香园论坛
图片尺寸559x232
biosharp bl512a 胰酶细胞消化液(酚红)100ml
图片尺寸800x800
029980 palcam琼脂平板 即用成品 90mm-广东环凯生物
图片尺寸2234x2441
25200056-胰蛋白酶-edta(0.25%),酚红
图片尺寸600x585
phenol red 酚红 苯酚红 amresco0882 生化科研试剂 143-74-8 5g
图片尺寸800x800
"rpmi medium 1640 (含双抗和酚红)"询价
图片尺寸500x500
水溶伊红
图片尺寸1600x1200










![酚红 苯酚红 ind指示剂 phenol red 25g [ph0623 phygene]](https://imgs.wantubizhi.com/img/31326CE759A4D648D73F1BAC447D16C0E810A9B3DE856EA250F60E3DF0E3673F7F33FF3E3DE4A11AD15A88CAE0E1AE72C6B75DE0322AA7969223F0B1A5F66FA800B6C9032423B87889C2747219D2A761CF449D89E1A8293E6850ABB19811877B)

![酚红 苯酚红 ind指示剂 phenol red 25g [ph0623 phygene]](http://img.alicdn.com/bao/uploaded/i1/3152001155/O1CN019M0srf1KP272BIzWG_!!3152001155.jpg)








